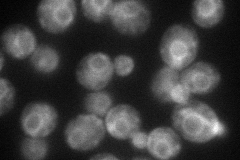
YNL323W
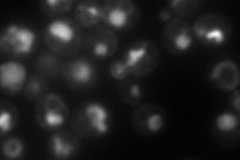
YNL323W
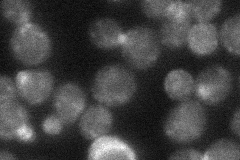
YNL323W
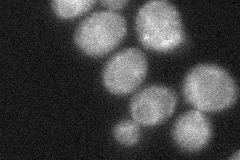
YNL323W
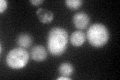
YNL323W
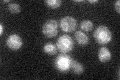
YNL323W

View description
Membrane protein of the plasma membrane and ER, interacts specifically in vivo with the phospholipid translocase (flippase) Dnf1p; involved in translocation of phospholipids and alkylphosphocholine drugs across the plasma membrane
Localization:
Intensity:
Fold change:
Significance:
-
C’ GFP library in SD

ER36.87 -
N' NOP1pr-GFP in SD
ER84.1242 -
N' TEF2pr-mCherry in SD
vacuole92.094 -
N' NATIVEpr-GFP in SD
punctate,bud neck28.7993 -
N' TEF2pr-VC and Cyto-VN in SD
punctate34.79 -
C’ GFP library in SD+DTT
ER35.270.95No -
C’ GFP library in SD+H2O2

ER33.170.89No -
C’ GFP library in Starvation Media
ER35.980.97No -
C’ GFP library on the background of Pup2-DaMP

ER -
C’ GFP library on the background of CCT mutant

ER29.59410.802541No
